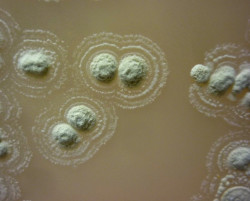
Consiguen las primeras im&aacute;genes de la estructura bacteriana para ayudar a combatir las superbacterias

Los pediatras proponen una apertura gradual de las escuelas en función de edad y situación epidemiológica
La Asociación Española de Pediatría (AEP) ha elaborado una propuesta para la apertura "gradual y escalonada" de escuelas y colegios en la que sugiere que se produzca en función de la situación epidemiológica local y la edad de los escolares.